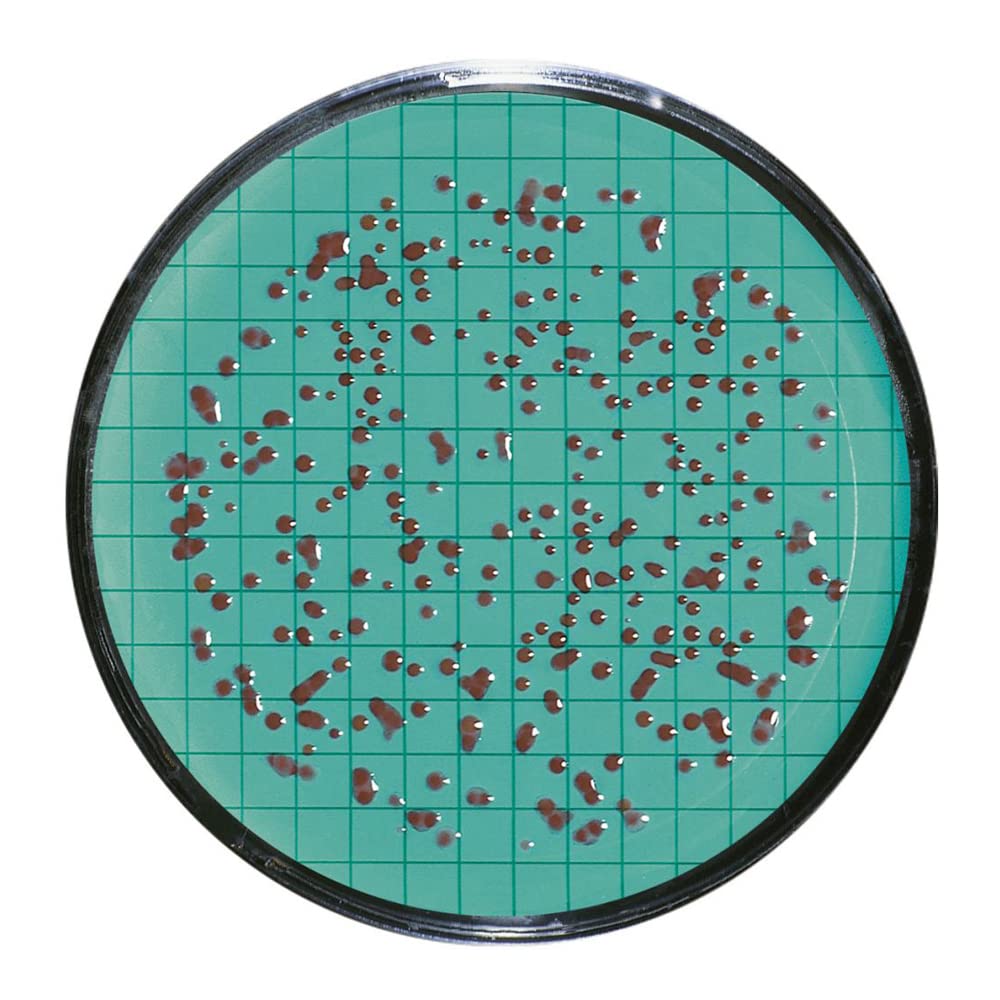
Sartorius 14055-47-RDN Nutrient Pad Sets, Dehydrated Media Pads in Petri Dishes with Matching Microsart Filters, Total Count, Standard TTC, 47 mm (Pack of 100)

Lab Dish Tee Experiment by atthemoment
$90.00
Price when purchased online
Free shipping
Free 30-day returns
Sold and shipped by wafi-egypt.com
We aim to show you accurate product information. Manufacturers, suppliers and others provide what you see here.
$90.00
Price when purchased online
Free shipping
Free 30-day returns
Sold and shipped by wafi-egypt.com
Free 30-day returns Details
Product details
| Management number | 211014268 | Release Date | 2026/04/04 | List Price | $36.00 | Model Number | 211014268 | ||
|---|---|---|---|---|---|---|---|---|---|
| Category | |||||||||
A Petri dish experiment facilitates the growth and observation of microorganisms, cells, or small plants in a shallow, round dish filled with a nutrient-rich medium. This controlled setting enables scientists to study biological processes, test substance effects, and cultivate cultures for research. Commonly used in microbiology, these experiments offer valuable insights into the behavior and characteristics of various organisms.
- Aged Appearance: Features a vintage print and wash effect
| Color | Black |
|---|---|
| Seasons | All |
| Fit Type | Loose Fit |
| Brand Name | AT THE MOMENT |
| Manufacturer | atthemoment |
| Occasion Type | Vacation |
| Collection Name | T-Shirts |
| Age Range Description | Adult |
| Item Length Description | Standard Length |
| Manufacturer Part Number | TE-04ABLK-158600 |
| Product Care Instructions | Hand Wash Only |
Correction of product information
If you notice any omissions or errors in the product information on this page, please use the correction request form below.
Correction Request Form